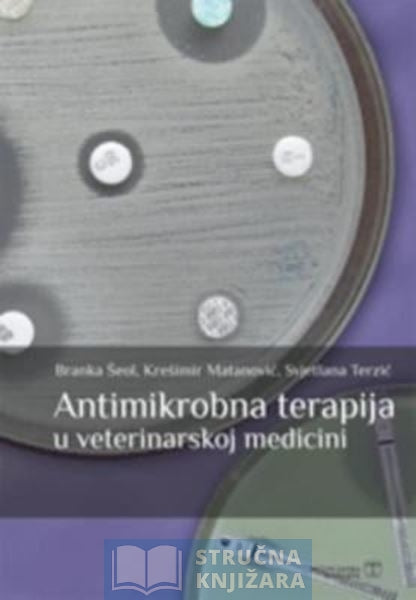

Stručna Knjižara
Share
Antimikrobna terapija u veterinarskoj medicini - Branka Šeol, Svjetlana Terzić, Krešimir Matanović
Antimikrobna terapija u veterinarskoj medicini - Branka Šeol, Svjetlana Terzić, Krešimir Matanović
Učitavanje dostupnosti preuzimanje nije moguće
Česta pitanja
Koji su Načini plaćanja?
Koji su Načini plaćanja?
- Kreditnom ili debitnom karticom
- Pouzećem – plaćanje po primitku paketa direktno djelatniku pošte
- Virmanom (uplata na žiro račun) -plaćanje Internet bankarstvom, uplatnicom u pošti, banci
Koliki su troškovi poštarine i koji je rok isporuke?
Koliki su troškovi poštarine i koji je rok isporuke?
Iznos narudžbe (vrijednost košarice) i troškovi slanja na adrese u Republici Hrvatskoj
Do 150,00 € -> 7,00 €
Iznad 150,00 € -> Gratis
Iznos narudžbe (vrijednost košarice) i troškovi slanja u inozemstvo
Do 26,54 € -> 20,97 €
Za svakih slijedećih 26,54 € vrijednosti košarice (do maksimalne vrijednosti košarice 132,72 €) dodaje se 5,30 €
Od 132,72 € vrijednosti košarice nadalje trošak dostave iznosi 46,18 €
Rok isporuke je od 14 do 30 radnih dana (u radne dane ne spadaju vikendi, blagdani i državni praznici).
U slučaju nepredviđene situacije, rok dostave može se produljiti, ali o tome ćete biti naknadno obaviješteni (mailom ili telefonski).
Da li je moguće osobno preuzimanje naručenih knjiga na adresi?
Da li je moguće osobno preuzimanje naručenih knjiga na adresi?
Kada su knjige dostupne, moguće je osobno preuzimanje knjiga na adresi ureda Ivane Brlić Mažuranić 72 (Malešnica), 10090 Zagreb uz obaveznu prethodnu najavu na telefon 00385 (0)1 3731 748.
Trebate pomoć oko kupovine putem naše internet stranice www.strucnaknjizara.com?
Trebate pomoć oko kupovine putem naše internet stranice www.strucnaknjizara.com?
Slobodno nas kontaktirajte putem naše e-mail adrese: info@strucnaknjizara.com ili telefonski na broj: 00385 (0)1 3731 748.
Ako se ne snalazite ili ne želite naručiti knjige preko internet trgovine, slobodno nam pošaljite direktan upit/narudžbu na e-mail na info@strucnaknjizara.com.
Za narudžbu su potrebni sljedeći podaci:
Točan naslov željene knjige i količina,
ime i prezime,
adresa dostave,
e-mail adresa i
telefonski broj.
Tražite stručnu knjigu i ne možete da ju pronađete?
Javite nam, potrudit ćemo se da je pronađemo za Vas.
Newsletter prijava
...prijavi se na listu i prati akcije